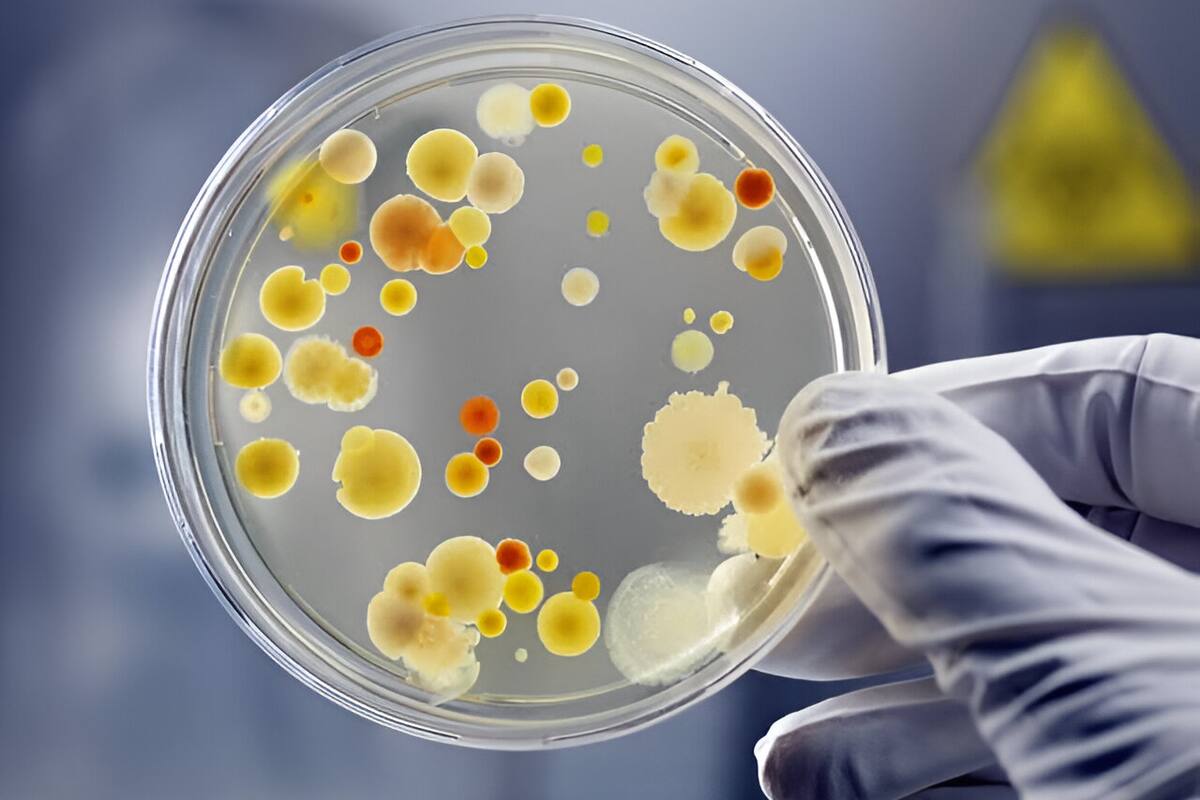
¿Qué es una bacteria?

¿Qué es una bacteria?
Lejos de ser todas dañinas, muchas de ellas son beneficiosas para la salud humana.
Las bacterias, bajo el lente del microscopio, revelan una diversidad sorprendente. Lejos de ser todas dañinas, muchas de ellas son beneficiosas para la salud humana. MedlinePlus, un servicio de la Biblioteca Nacional de Medicina (NLM) de Estados Unidos, destaca que algunos de estos microorganismos desempeñan roles esenciales en la digestión, la destrucción de células patógenas y el suministro de vitaminas esenciales para el cuerpo.
National Geographic, en sus artículos, detalla qué son las bacterias, sus diversas formas y roles, así como su impacto tanto en la naturaleza como en la salud humana.
Qué son las bacterias y dónde se encuentran
El Instituto Nacional de Investigación del Genoma Humano (NHGRI) de Estados Unidos describe a las bacterias como organismos procariotas unicelulares que se encuentran en casi todas las partes de la Tierra. Son vitales para los ecosistemas del planeta, y algunas especies pueden sobrevivir en condiciones extremas de temperatura y presión.
El cuerpo humano alberga una cantidad impresionante de estos microorganismos, superando incluso el número de células humanas. La mayoría de estas bacterias son inofensivas e, incluso, beneficiosas. Solo una pequeña fracción de las especies bacterianas son patógenas y pueden causar enfermedades.
Estos microorganismos presentan diversas formas: esféricas, alargadas o espirales. En el sistema digestivo, especialmente en el intestino, existen bacterias esenciales para el buen funcionamiento del cuerpo humano, ayudando en la digestión y la absorción de nutrientes.
Enfermedades graves causadas por bacterias
A pesar de los beneficios de muchas bacterias, algunas pueden causar enfermedades graves, y algunas cepas incluso desarrollan resistencia a los tratamientos. Entre estas enfermedades se encuentra la salmonelosis, causada por la bacteria Salmonella, que puede provocar infecciones graves e incluso la muerte.
Otras enfermedades bacterianas incluyen la leptospirosis, causada por bacterias del género Leptospira, presentes en la orina de las ratas y también potencialmente mortal; y la meningitis bacteriana, que afecta a las meninges (membranas que rodean el cerebro y la médula espinal) causando una inflamación grave y siendo altamente transmisible.
Estas enfermedades son solo algunas de las más comunes, según la Organización Mundial de la Salud (OMS) y el Ministerio de Sanidad de Brasil.
Te puede interesar: Ni la manzana ni la fresa: esta es la fruta más consumida a nivel mundial
Las bacterias, en su diversidad y ubicuidad, desempeñan roles cruciales en la salud humana y el medio ambiente, aunque también pueden ser responsables de enfermedades graves. La investigación y los avances médicos continúan explorando estos microorganismos, buscando entender mejor su impacto y cómo aprovechar sus beneficios mientras se mitigan sus riesgos.
Sigue nuestro canal de WhatsApp
Recibe las noticias más importantes del día. Da click aquí